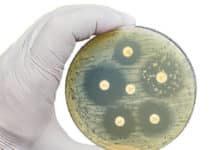
Tierarzneimittelgesetz: Neue Regeln zum Antibiotikaeinsatz

Tierarzneimittelgesetz: Neue Regeln zum Antibiotikaeinsatz
Antibiotikaeinsatz – so wenig wie möglich, so viel wie nötig – mit dieser Zielsetzung hat Gesundheitsminister Johannes Rauch ein neues Tierarzneimittelgesetz erstellt, das die...
Heumilchbauern tragen mit angepasster Grünlandwirtschaft zum Klimaschutz bei
Eine an die natürlichen Gegebenheiten angepasste Bewirtschaftung des Grünlands trägt bei zu Artenvielfalt und Bodengesundheit, diesen Leitsatz formulierte der Umweltökologe der HBLFA Raumberg-Gumpenstein, Dr....
Milchleistungskontrolle wird mit 13 Millionen Euro unterstützt
Ende Juni hat die Agrarmarkt Austria den Kontrollkostenzuschuss im Rahmen des Qualitätsprogramms Q-plus ausbezahlt. In Summe kamen an die rund 18.000 teilnehmenden heimischen Betriebe...
Schweinebauern brauchen wirksamen Investitionsschutz
BAUERNZEITUNG: Die Erzeugerpreise für Schlachtschweine und Ferkel sind auf Rekordniveau. Dennoch ist die Stimmung unter den Bauern gedämpft. Warum?
Rauscher: Hohe Preise bedeuten nicht automatisch...
Grünland: Güllekalk verdrängt lästige Wiesenunkräuter
Kalk als Unkrautvernichter? Dieser nützliche Aspekt einer Kalkung ist weniger bekannt, als er es verdient. Denn neben der bekannten pH-Pufferung von Bodensäuren kann Kalk...
AMA Fleischforum: Dänemarks Schweinesektor offensiv beim Klimaschutz
Vision 2050, unter diesem Titel arbeiten der dänische Schweinesektor und der Dänische Fachverband der Land- und Ernährungswirtschaft an einem ambitionierten Programm, um die Produktion...
Milchmarkt Mai ’23: Rohstoffwert zeigt Marktfestigung an
Die für Milch aus Österreich bedeutsamen Absatzmärkte in Italien und Deutschland zeigen nach monatelangen Preisrücknahmen eine Stabilisierung an. So befestigte sich die Spotmilchnotierung in...
AMA Milchforum: Milch kommt von der Kuh, nicht vom Hafer
Hafermilch ist ein Reizwort für Milchbauern und Milchverarbeiter. So auch beim AMA-Milchforum am Mittwoch, 31. Mai, zu dem die AMA-Marketing nach Wien eingeladen hat....
Siliermittel richtig auswählen
Fehlgärungen vermeiden, Nacherwärmung verringern, die Schmackhaftigkeit des Futters verbessern – das sind die Motive für den Einsatz von Siliermitteln. Orientierung unter der Vielzahl an...
Echter „Megastar”: Erstmals genetisch hornloser Fleckviehstier weltweit auf Platz 1
Das gab es bislang noch nie! Erstmals wird die Liste der besten Fleckviehstiere weltweit von einem genetisch hornlosen Stier angeführt. Die Rede ist von...